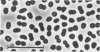

Abstract
A toluene-degrading sulfate-reducing bacterium, strain Tol2, was isolated from marine sediment under strictly anoxic conditions. Toluene was toxic if applied directly to the medium at concentrations higher than 0.5 mM. To provide toluene continuously at a nontoxic concentration, it was supplied in an inert hydrophobic carrier phase. The isolate had oval, sometimes motile cells (1.2 to 1.4 by 1.2 to 2.0 microns). The doubling time was 27 h. Toluene was completely oxidized to CO2, as demonstrated by measurement of the degradation balance. The presence of carbon monoxide dehydrogenase and formate dehydrogenase indicated a terminal oxidation of acetyl coenzyme A via the CO dehydrogenase pathway. The use of hypothetical intermediates of toluene degradation was tested in growth experiments and adaptation studies with dense cell suspensions. Results do not support a degradation of toluene via one of the cresols or methylbenzoates, benzyl alcohol, or phenylacetate as free intermediate. Benzyl alcohol did not serve as growth substrate; moreover, it was a strong, specific inhibitor of toluene degradation, whereas benzoate utilization was not affected by benzyl alcohol. Sequencing of 16S rRNA revealed a relationship to the metabolically dissimilar genus Desulfobacter and on a deeper level to the genus Desulfobacterium. The new genus and species Desulfobacula toluolica is proposed.
Full text
PDF







Images in this article
Selected References
These references are in PubMed. This may not be the complete list of references from this article.
- Altenschmidt U., Fuchs G. Anaerobic degradation of toluene in denitrifying Pseudomonas sp.: indication for toluene methylhydroxylation and benzoyl-CoA as central aromatic intermediate. Arch Microbiol. 1991;156(2):152–158. doi: 10.1007/BF00290990. [DOI] [PubMed] [Google Scholar]
- Altenschmidt U., Fuchs G. Anaerobic toluene oxidation to benzyl alcohol and benzaldehyde in a denitrifying Pseudomonas strain. J Bacteriol. 1992 Jul;174(14):4860–4862. doi: 10.1128/jb.174.14.4860-4862.1992. [DOI] [PMC free article] [PubMed] [Google Scholar]
- Beller H. R., Grbić-Galić D., Reinhard M. Microbial degradation of toluene under sulfate-reducing conditions and the influence of iron on the process. Appl Environ Microbiol. 1992 Mar;58(3):786–793. doi: 10.1128/aem.58.3.786-793.1992. [DOI] [PMC free article] [PubMed] [Google Scholar]
- Beller H. R., Reinhard M., Grbić-Galić D. Metabolic by-products of anaerobic toluene degradation by sulfate-reducing enrichment cultures. Appl Environ Microbiol. 1992 Sep;58(9):3192–3195. doi: 10.1128/aem.58.9.3192-3195.1992. [DOI] [PMC free article] [PubMed] [Google Scholar]
- Bradford M. M. A rapid and sensitive method for the quantitation of microgram quantities of protein utilizing the principle of protein-dye binding. Anal Biochem. 1976 May 7;72:248–254. doi: 10.1016/0003-2697(76)90527-3. [DOI] [PubMed] [Google Scholar]
- Brosius J., Dull T. J., Sleeter D. D., Noller H. F. Gene organization and primary structure of a ribosomal RNA operon from Escherichia coli. J Mol Biol. 1981 May 15;148(2):107–127. doi: 10.1016/0022-2836(81)90508-8. [DOI] [PubMed] [Google Scholar]
- Dolfing J., Zeyer J., Binder-Eicher P., Schwarzenbach R. P. Isolation and characterization of a bacterium that mineralizes toluene in the absence of molecular oxygen. Arch Microbiol. 1990;154(4):336–341. doi: 10.1007/BF00276528. [DOI] [PubMed] [Google Scholar]
- Edwards E. A., Grbić-Galić D. Complete mineralization of benzene by aquifer microorganisms under strictly anaerobic conditions. Appl Environ Microbiol. 1992 Aug;58(8):2663–2666. doi: 10.1128/aem.58.8.2663-2666.1992. [DOI] [PMC free article] [PubMed] [Google Scholar]
- Evans P. J., Ling W., Goldschmidt B., Ritter E. R., Young L. Y. Metabolites formed during anaerobic transformation of toluene and o-xylene and their proposed relationship to the initial steps of toluene mineralization. Appl Environ Microbiol. 1992 Feb;58(2):496–501. doi: 10.1128/aem.58.2.496-501.1992. [DOI] [PMC free article] [PubMed] [Google Scholar]
- Evans P. J., Mang D. T., Kim K. S., Young L. Y. Anaerobic degradation of toluene by a denitrifying bacterium. Appl Environ Microbiol. 1991 Apr;57(4):1139–1145. doi: 10.1128/aem.57.4.1139-1145.1991. [DOI] [PMC free article] [PubMed] [Google Scholar]
- Kuhn E. P., Zeyer J., Eicher P., Schwarzenbach R. P. Anaerobic degradation of alkylated benzenes in denitrifying laboratory aquifer columns. Appl Environ Microbiol. 1988 Feb;54(2):490–496. doi: 10.1128/aem.54.2.490-496.1988. [DOI] [PMC free article] [PubMed] [Google Scholar]
- Lovley D. R., Lonergan D. J. Anaerobic Oxidation of Toluene, Phenol, and p-Cresol by the Dissimilatory Iron-Reducing Organism, GS-15. Appl Environ Microbiol. 1990 Jun;56(6):1858–1864. doi: 10.1128/aem.56.6.1858-1864.1990. [DOI] [PMC free article] [PubMed] [Google Scholar]
- MARMUR J., DOTY P. Determination of the base composition of deoxyribonucleic acid from its thermal denaturation temperature. J Mol Biol. 1962 Jul;5:109–118. doi: 10.1016/s0022-2836(62)80066-7. [DOI] [PubMed] [Google Scholar]
- Olsen G. J., Overbeek R., Larsen N., Marsh T. L., McCaughey M. J., Maciukenas M. A., Kuan W. M., Macke T. J., Xing Y., Woese C. R. The Ribosomal Database Project. Nucleic Acids Res. 1992 May 11;20 (Suppl):2199–2200. doi: 10.1093/nar/20.suppl.2199. [DOI] [PMC free article] [PubMed] [Google Scholar]
- Schnell S., Bak F., Pfennig N. Anaerobic degradation of aniline and dihydroxybenzenes by newly isolated sulfate-reducing bacteria and description of Desulfobacterium anilini. Arch Microbiol. 1989;152(6):556–563. doi: 10.1007/BF00425486. [DOI] [PubMed] [Google Scholar]
- Schocher R. J., Seyfried B., Vazquez F., Zeyer J. Anaerobic degradation of toluene by pure cultures of denitrifying bacteria. Arch Microbiol. 1991;157(1):7–12. doi: 10.1007/BF00245327. [DOI] [PubMed] [Google Scholar]
- Thauer R. K., Jungermann K., Decker K. Energy conservation in chemotrophic anaerobic bacteria. Bacteriol Rev. 1977 Mar;41(1):100–180. doi: 10.1128/br.41.1.100-180.1977. [DOI] [PMC free article] [PubMed] [Google Scholar]
- Tschech A., Fuchs G. Anaerobic degradation of phenol by pure cultures of newly isolated denitrifying pseudomonads. Arch Microbiol. 1987 Sep;148(3):213–217. doi: 10.1007/BF00414814. [DOI] [PubMed] [Google Scholar]
- Vogel T. M., Grbìc-Galìc D. Incorporation of Oxygen from Water into Toluene and Benzene during Anaerobic Fermentative Transformation. Appl Environ Microbiol. 1986 Jul;52(1):200–202. doi: 10.1128/aem.52.1.200-202.1986. [DOI] [PMC free article] [PubMed] [Google Scholar]
- Widdel F., Pfennig N. Studies on dissimilatory sulfate-reducing bacteria that decompose fatty acids. I. Isolation of new sulfate-reducing bacteria enriched with acetate from saline environments. Description of Desulfobacter postgatei gen. nov., sp. nov. Arch Microbiol. 1981 Jul;129(5):395–400. doi: 10.1007/BF00406470. [DOI] [PubMed] [Google Scholar]